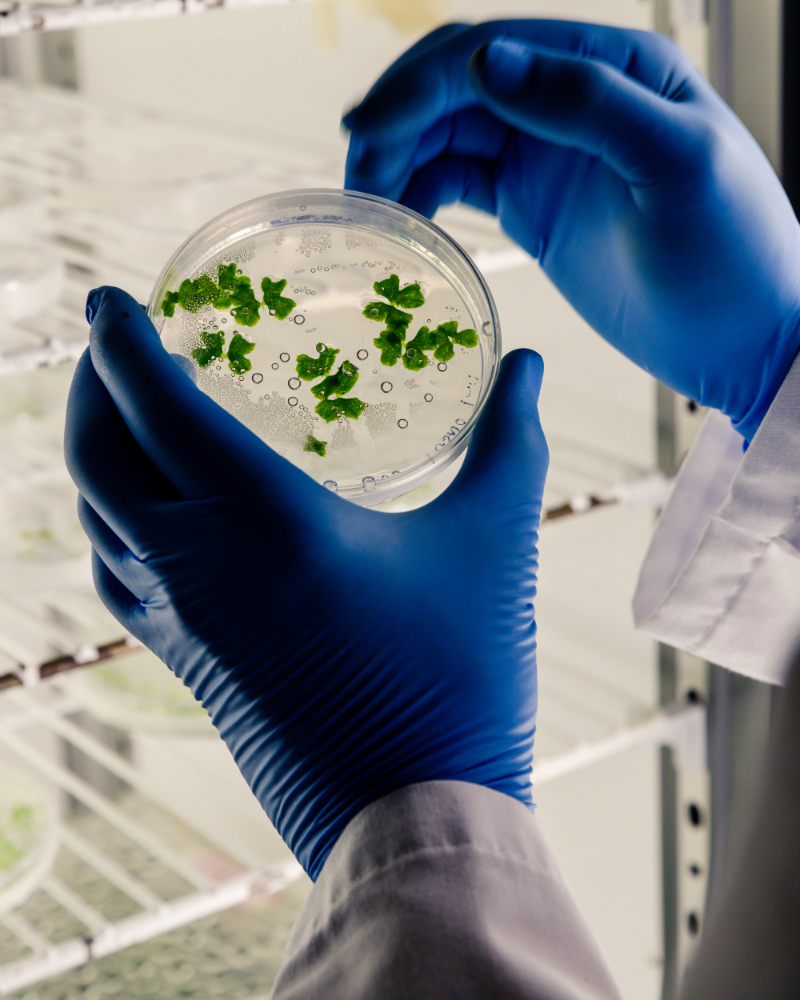
1105

من نحن
مختبر رائد لفحص مواد البناء بخبرة موثوقة
مختبر البلاع لفحص مواد البناء لأكثر من 35 عاماً يمارس مهامه كمختبر رائد في مجال هندسة المواد والجيوتقنية وأعمال فحص التربة والأساسات معتمدا على أحدث الأجهزة الحقلية والمعملية والعديد من المهندسين المؤهلين وذوي الخبرة والفنيين المميزين ويقدم خدماته بجودة عالية وموثوقية وحيادية مع سمعة رفيعة وتماشيا مع رؤية المملكة 2030 للنهوض بالعمل واحترافية الإنجاز


رؤيتنا
ريادة هندسية مواكبة لرؤية السعودية 2030
من منطلق الإيمان بوطننا ورؤية قيادته الحكيمة 2030 فإننا نرسم رؤيتنا بما يواكب رؤية الوطن من ريادة الأعمال وتقديم خدمات هندسية متخصصة وتوطين الوظائف وخلق تنافسية محلية وعالمية وتقنيات متطورة بمواصفات عالمية

أهدافنا
التميز والجودة المستدامة
تلتزم في مختبر البلاع بإنشاء وتنفيذ وصيانة نظام متكامل لإدارة الجودة يضمن استمرارية التميز في جميع خدماتنا. نسعى لتقديم خدمات معملية وفقاً لأعلى المعايير العالمية وبما يتوافق مع متطلبات هيئات الاعتماد وتوقعات عملائنا، حيث نهتم بأدق التفاصيل ولا نترك مجالاً للتقصير. نؤمن بأن عملاءنا يستحقون أن يكونوا مميزين مثل الفحوصات التي نقدمها لهم، لذلك نحرص على تلبية أعلى توقعاتهم بل وتجاوزها من خلال دقة الأداء واحترافية التنفيذ. كما نوفر بيئة عمل آمنة ومحفزة تضمن جودة النتائج واستدامة النجاح


قيمنا
نلتزم بالشفافية، الجودة، الابتكار وخدمة العملاء
قيمنا تمثل الأساس الذي يقوم عليه عملنا، وهي الضمانة لاستمرارية نجاحنا وثقة عملائنا
الولاء والانتماء
التمسك بقيم المجتمع والالتزام بالأنظمة
رضا العملاء
وضع العميل في قلب اهتماماتنا وتقديم نتائج دقيقة وموثوقة
التعلم والنمو
مواكبة كل ما هو جديد في التقنيات والمعايير
الإبداع والمبادرة
السعي للتفرد والتميز في الحلول المقدمة
الشفافية والنزاهة
الالتزام بالحياد والسرية التامة في جميع أعمالنا



نقدم فحوصات دقيقة لمواد البناء لضمان مطابقتها للمواصفات والمعايير العالمية، لديكم قائمة بأهم التجارب التي يقوم بها المختبر

الهندسة الجيوتقنية
تحليل التربة والأساسات لتحديد قدرتها على تحمل المنشآت، باستخدام أحدث المعدات والتقنيات الهندسية.

اختبارات التربة
إجراء اختبارات متقدمة للتربة لتحديد الخصائص الفيزيائية والميكانيكية، لضمان الاستقرار والمتانة في المشاريع.

الاستشارات الهندسية
تقديم حلول واستشارات متخصصة في مجال هندسة المواد والتربة لتلبية متطلبات المشاريع المختلفة

فحص الأساسات
تقييم وفحص الأساسات لضمان متانتها وسلامتها وفق أعلى معايير الجودة العالمية

التحليل المخبري المتقدم
إجراء اختبارات مخبرية متقدمة على المواد الهندسية لضمان الدقة والموثوقية في النتائج


